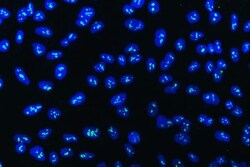

Learn More
Invitrogen™ WDR3 Polyclonal Antibody


Rabbit Polyclonal Antibody
Supplier: Invitrogen™ PA5144030
Description
Adding 0.2 mL of distilled water will yield a concentration of 500 μg/mL. Positive Control - WB: human Hela whole cell, human 293T whole cell, human U251 whole cell. ICC/IF: A549 cell. Flow: Daudi cell. Store at -20°C for one year from date of receipt. After reconstitution, at 4°C for one month. It can also be aliquotted and stored frozen at -20°C for six months. Avoid repeated freeze-thaw cycles.
This gene encodes a nuclear protein containing 10 WD repeats. WD repeats are approximately 30- to 40-amino acid domains containing several conserved residues, which usually include a trp-asp at the C-terminal end. Proteins belonging to the WD repeat family are involved in a variety of cellular processes, including cell cycle progression, signal transduction, apoptosis, and gene regulation. [provided by RefSeq, Jul 2008].
Specifications
| WDR3 | |
| Polyclonal | |
| Unconjugated | |
| WDR3 | |
| DIP2; dJ776P7.2 (WD repeat domain 3); UTP12; WD repeat domain 3; WD repeat-containing protein 3; WDR3 | |
| Rabbit | |
| Antigen affinity chromatography | |
| RUO | |
| 10885 | |
| -20°C | |
| Lyophilized |
| ELISA, Flow Cytometry, Western Blot, Immunocytochemistry | |
| 500 μg/mL | |
| PBS with 4mg trehalose and no preservative | |
| Q9UNX4 | |
| WDR3 | |
| E.coli-derived human WDR3 recombinant protein (Position: M1-E927). | |
| 100 μg | |
| Primary | |
| Human | |
| Antibody | |
| IgG |
Your input is important to us. Please complete this form to provide feedback related to the content on this product.